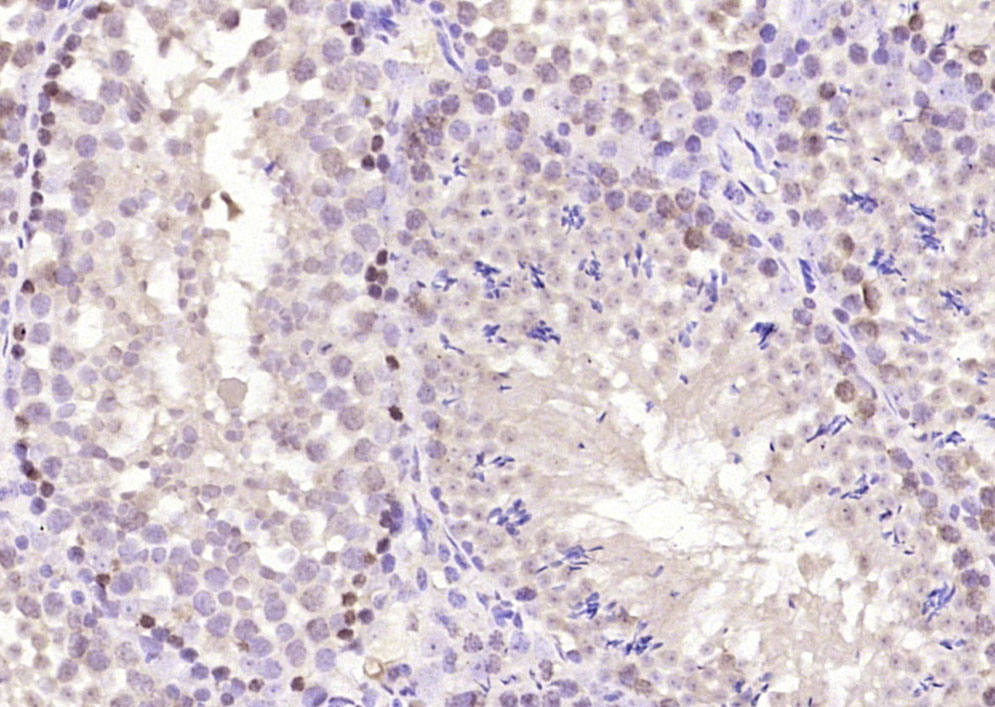
phospho-CREM (Ser271 + Ser274)

相关产品推荐更多 >

Anti-human PTGFRN / CD315 (AG02-ADC Biosimilar)(BIO0364SM)-1mg/5mg/20mg
¥3200
HPV16 E7 Rabbit pAb, Cy5.5 conjugated(bs-0714R-Cy5.5)-100ul
¥2980
TP53INP2 Rabbit pAb(bs-17160R)-50ul/100ul/200ul
¥1180
hTau40 Mouse mAb(bsm-41722M)-100ul/50ul/200ul/200ug
¥1180
MPO Rabbit pAb, BF488 conjugated(bs-4943R-BF488)-100ul
¥2980
万千商家帮你免费找货
0 人在求购买到急需产品
- 详细信息
- 文献和实验
- 技术资料
- 应用范围:
产品信息以Bioss网站为准
- 规格:
50ul/100ul/200ul
| 规格: | 50ul | 产品价格: | ¥1180.0 |
|---|---|---|---|
| 规格: | 100ul | 产品价格: | ¥1980.0 |
| 规格: | 200ul | 产品价格: | ¥2800.0 |
| 产品编号 | bs-4066R |
| 英文名称 | phospho-CREM (Ser271 + Ser274) Rabbit pAb |
| 中文名称 | 磷酸化环磷酸腺苷反应元件调节蛋白抗体 |
| 英文别名 | CREM(phospho S271+S274); p-CREM(phospho S271+S274); cAMP response element modulator; cAMP responsive element modulator; hCREM 2; hCREM2; ICER; Inducible cAMP early repressor; Inducible cAMP early repressor ICER; MGC111110; MGC17881; MGC41893. |
| 产品应用 | IHC-P=1:100-500, IHC-F=1:100-500, IF=1:100-500 Not yet tested in other applications. |
| 交叉反应 | Mouse, Rat (Human, Chicken, Pig, Horse) |
| 抗体来源 | Rabbit |
| 免疫原 | KLH conjugated Synthesised phosphopeptide derived from human CREM around the phosphorylation site of Ser271 + Ser274 |
| 亚型 | IgG |
| 性状 | Liquid |
| 纯化方法 | affinity purified by Protein A |
| 克隆类型 | Polyclonal |
| 理论分子量 | 37 kDa |
| 浓度 | 1mg/ml |
| 储存液 | 0.01M TBS (pH7.4) with 1% BSA, 0.02% Proclin300 and 50% Glycerol. |
| 研究领域 | Signal Transduction > Second Messenger > Nucleotide Messenger > cAMP |
| 亚基 | Binds DNA as a dimer. Interacts with FHL5. Interacts with CDC34. |
| 亚细胞定位 | Nucleus. |
| 组织特异性 | Expressed in testes (round spermatids) (at protein level). Isoform 14 is the major activator form in testes. |
| 翻译后修饰 | Isoform 9 is ubiquitinated by CDC34 and RAD6B in order to be degraded by the proteasome.
Stimulated by phosphorylation. |
| 相似性 | Belongs to the bZIP family. Contains 1 bZIP domain. Contains 1 KID (kinase-inducible) domain. |
| 功能 | Transcriptional regulator that binds the cAMP response element (CRE), a sequence present in many viral and cellular promoters. Isoforms are either transcriptional activators or repressors. Plays a role in spermatogenesis and is involved in spermatid maturation. |
| 保存条件 | Shipped at 4℃. Store at -20℃ for one year. Avoid repeated freeze/thaw cycles. |
| 注意事项 | This product as supplied is intended for research use only, not for use in human, therapeutic or diagnostic applications. |
| 背景资料 | CREM is a a bZIP transcription factor that binds to the cAMP responsive element found in many viral and cellular promoters. It is derived from a multiexonic gene that encodes both activators and antagonists of cAMP-inducible transcription by differential splicing. Splice variants with antagonistic function lack 2 glutamine-rich domains and block cAMP-induced transcription, whereas an isoform that includes these glutamine-rich domains is a transcriptional activator. |
| 应用 | 推荐稀释比例 |
| {IHC-P} | {1:100-500} |
| {IHC-F} | {1:100-500} |
| {IF} | {1:100-500} |

风险提示:丁香通仅作为第三方平台,为商家信息发布提供平台空间。用户咨询产品时请注意保护个人信息及财产安全,合理判断,谨慎选购商品,商家和用户对交易行为负责。对于医疗器械类产品,请先查证核实企业经营资质和医疗器械产品注册证情况。
文献和实验:使用 Anti-phospho-Akt (Ser473) Rabbit mAb 对石蜡包埋的人乳腺癌组织进行免疫组织化学分析。(图 A)使用免疫组化试剂盒M&R HRP/DAB Detection IHC Kit,抗体 1:100 稀释;(图 B) 采用普通免疫组化试剂盒,抗体 1:25 稀释。 图 6 免疫组化实验检测 Erk1/2 表达 注:使用 Anti-Erk1/2 Mouse mAb与p44/42 MAPK (Erk1/2)Rabbit mAb 对正常小鼠心脏组织进行免疫
at 10, 25, and 50 μM). At 24 h post-treatment, celllysates were obtained; SDS-PAGE and Western blotting were performed as described in Section 3, Methods. AR-A014418dose-dependent decreases of phospho-β-catenin (Ser33/37) and phospho-glycogen synthase
(Ser473)(193H12)Rabbit mAb,1:300,稀释,二抗是驴抗兔,1:2000,我是实验室的新手,刚呆俩月,受 此挫折,一头雾水,请过来人或者有经验的同学帮忙解答怎样解决,非常感谢! 碧峤 pAkt有两个位点,Ser473和Thr308,其中Ser473相对容易显色。如果显色失败,可能的原因:1 上样量过少,我们一般都是30μg;2 一抗孵育时间过短,我们一般24h~48h;3 一抗是否工作有待排除 米宝
技术资料暂无技术资料 索取技术资料






